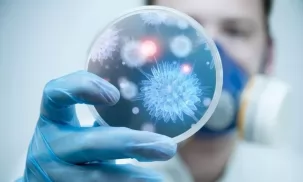

В СНГ вводят меры поддержки медиков, бизнеса и граждан
3 апреля 2020
В Казахстане начали разработку вакцины от коронавируса
27 марта 2020
В Исполкоме СНГ создана Рабочая группа по мониторингу ситуации, связанной с пандемией коронавирусной инфекции COVID-19
Рекомендации ВОЗ для населения в связи c распространением коронавирусной инфекции (COVID-19)
Азербайджан
Постановление Кабинета Министров от 19 мая 2020 № 179
Постановление Кабинета Министров от 16 мая 2020 № 175
Постановление Кабинета Министров от 16 мая 2020 № 178
Постановление Кабинета Министров от 1 мая 2020 № 160
Постановление Кабинета Министров от 1 мая 2020 № 161
Постановление Кабинета Министров от 1 мая 2020 № 163
Постановление Кабинета Министров от 24 апреля 2020 № 147
Постановление Кабинета Министров от 27 апреля 2020 № 152
Постановление Кабинета Министров от 18 апреля 2020 № 144
Решение Кабинета Министров от 13 апреля 2020 года «Об оплате расходов на обучение студентов из семей, относящихся к социально уязвимой группе населения»
Распоряжение Президента Азербайджанской Республики «О ряде мер по снижению негативного влияния пандемии коронавируса (COVID-19) и вызванных ею резких колебаний, происходящих на мировых энергетических рынках и рынках акций, на экономику Азербайджанской Республики, макроэкономическую стабильность, вопросы занятости в стране и субъектов предпринимательства»
Распоряжение Президента Азербайджанской Республики «О выделении средств Фонду поддержки борьбы с коронавирусом для здравоохранительных мероприятий, осуществляемых против коронавирусной инфекции в Азербайджанской Республике»
Указ Президента Азербайджанской Республики «О мерах по охране здоровья населения и усилению борьбы с коронавирусной инфекцией в Азербайджанской Республике»
Распоряжение Президента Азербайджанской Республики «Об усилении социальной защиты медицинских работников, участвующих в мероприятиях по борьбе с новым видом коронавирусной инфекции (COVİD-19)»
Армения
С 1 мая изменен порядок въезда на территорию Армении
Закон «О внесении дополнений в Уголовный кодекс Армении»
Закон «О внесении изменений и дополнений в Кодекс об административных правонарушениях»
Постановление Правительства Республики Армения № 298-n от 16 марта 2020 года «Об объявлении чрезвычайного положения в Республике Армения»
Беларусь
Приказ Министерства здравоохранения Республики Беларусь от 11.11.2020 г. № 1195 «Об изменении приказов Министерства здравоохранения Республики Беларусь от 5 июня 2020 г. № 615 и от 15 апреля 2020 № 433»
Постановление Совета Министров Республики Беларусь № 624 от 30 октября 2020 года О мерах по предотвращению распространения инфекционного заболевания
Приказ Министерства здравоохранения Республики Беларусь от 20.10.2020 г. № 1106 «О некоторых вопросах оказания медицинской помощи пациентов с инфекцией COVID-19»
Приказ Министерства здравоохранения Республики Беларусь от 09.10.2020 г. № 1067 «Об организации работы специалистов-координаторов по борьбе с инфекцией COVID-19»
Перечень действующих специфических санитарно-эпидемиологических требований, утвержденных постановлениями Совета Министров Республики Беларусь
Приказ Министерства здравоохранения Республики Беларусь от 11.09.2020 г. № 925 «О лабораторных исследованиях на COVID-19»
Приказ Министерства здравоохранения Республики Беларусь от 5 июня 2020 г. № 615 «Об оказания медицинской помощи пациентам с инфекцией COVID-19»
Указ от 28 мая 2020 г. № 178 «О временных мерах государственной поддержки нанимателей и отдельных категорий граждан»
Постановление Совета Министров Республики Беларусь от 22 мая 2020 г. № 305 «О мерах по предотвращению распространения инфекции, вызванной коронавирусом COVID-19»
Указ Президента Республики Беларусь от 24 апреля 2020 г. № 143 «О поддержке экономики»
Постановление Совета Министров от 14.04.2020 № 221 Об изменении постановления Совета Министров Республики Беларусь от 27 декабря 2019 г. № 923
Постановление Совета Министров Республики Беларусь от 8 апреля 2020 года № 208 «О введении ограничительного мероприятия»
Постановление Совета Министров Республики Беларусь от 3 апреля 2020 г. № 194 «О служебных командировках за границу»
Постановление Совета Министров от 25.03.2020 № 171 «О мерах по предотвращению завоза и распространения инфекции, вызванной коронавирусом COVID-19»
Постановление Совета Министров Республики Беларусь от 17 марта 2020 г. № 149 «О введении временного запрета на вывоз отдельных видов товаров из Республики Беларусь»
Приказ Министерства здравоохранения Республики Беларусь № 296 от 16 марта 2020 г. «О мерах по организации оказания медицинской помощи пациентам с признаками респираторной инфекции и принятию дополнительных противоэпидемических мер в организациях здравоохранения»
Постановление Совета Министров Республики Беларусь от 21 марта 2020 г. № 163 «О выделении средств из республиканского бюджета»
Казахстан
Новое постановление подписал главный санврач Казахстана
Постановление Главного государственного санитарного врача города Нур-Султан от 20 ноября 2020 года № ПГСВ-248 "Об ограничительных и карантинных мерах в городе Нур-Султан"
Постановление Главного государственного санитарного врача города Нур-Султан от 24 октября 2020 года № 245 "Об ограничительных и карантинных мерах в городе Нур-Султан"
Постановление Главного государственного санитарного врача города Нур-Султан от 13 октября 2020 года № ПГСВ-243 "Об ужесточении ограничительных и карантинных мер в городе"
Распоряжение Президента от 9 июля 2020 года «Об объявлении дня общенационального траура в Республике Казахстан в память о гражданах, ставших жертвами пандемии коронавируса»
Приказ Министра здравоохранения Республики Казахстан от 5 июля 2020 года № ҚР ДСМ-78/2020 «О некоторых вопросах организации и проведения санитарно-противоэпидемических и санитарно-профилактических мероприятий»
Постановление Главного государственного санитарного врача Республики Казахстан от 3 июля 2020 года № 44 «О введении строгих ограничительных карантинных мер»
Постановление Правительства Республики Казахстан от 30 марта 2020 года № 155 «О временном закрытии автомобильных пунктов пропуска на отдельных участках Государственной границы Республики Казахстан» (с изменениями и дополнениями по состоянию на 01.07.2020 г.)
Постановление Главного государственного санитарного врача Республики Казахстан от 25 июня 2020 года № 43 «О дальнейшем усилении мер по предупреждению заболеваний коронавирусной инфекцией среди населения Республики Казахстан»
Постановление Главного государственного санитарного врача Республики Казахстан от 24 июня 2020 года № 42 «О дальнейшем усилении мер по предупреждению заболеваний коронавирусной инфекцией в пунктах пропуска на государственной границе Республики Казахстан»
Постановление Главного государственного санитарного врача на транспорте от 29 мая 2020 года № 18 «О дальнейшем усилении мер по предупреждению заболеваний коронавирусной инфекцией COVID-19 среди населения при осуществлении железнодорожных перевозок»
Постановление Главного государственного санитарного врача на транспорте от 18 мая 2020 года № 11 «О недопущении организации объектов общественного питания в составах пассажирских поездов»
Постановление Главного государственного санитарного врача на транспорте от 14 мая 2020 года № 9 «О санитарно-карантинном контроле при возобновлении регулярных внутренних железнодорожных сообщений в Республике Казахстан» (с изменениями и дополнениями от 28.05.2020 г.)
Постановление Правительства Республики Казахстан от 20 марта 2020 года № 126 «О мерах по реализации Указа Президента Республики Казахстан от 16 марта 2020 года № 287 «О дальнейших мерах по стабилизации экономики» (с изменениями и дополнениями по состоянию на 06.05.2020 г.)
Постановление Правительства Республики Казахстан от 20 апреля 2020 года № 224 «О дальнейших мерах по реализации Указа Президента Республики Казахстан от 16 марта 2020 года № 287 «О дальнейших мерах по стабилизации экономики» по вопросам налогообложения»
Постановление Правительства Республики Казахстан от 17 апреля 2020 года №220
Указ Президента Республики Казахстан №306 от 14 апреля 2020 года «О продлении действия чрезвычайного положения в Республике Казахстан»
Совместный приказ Министр здравоохранения Республики Казахстан от 9 апреля 2020 года № ҚР ДСМ-35/2020 и Министра труда и социальной защиты населения Республики Казахстан от 9 апреля 2020 года № 129 «Об утверждении Правил осуществления единовременной социальной выплаты работникам организаций здравоохранения, задействованным в противоэпидемических мероприятиях по борьбе с коронавирусной инфекцией»
Приказ Министра здравоохранения Республики Казахстан от 4 апреля 2020 года № ҚР ДСМ-28/2020 «О некоторых вопросах финансовой поддержки работников организаций здравоохранения, задействованных в противоэпидемических мероприятиях в рамках борьбы с коронавирусом COVID-19»
Приказ Министра здравоохранения Республики Казахстан от 27 марта 2020 года № ҚР ДСМ-21/2020 «О внесении изменений и дополнений в некоторые приказы в области здравоохранения»
Указ Президента Республики Казахстан от 15.03.2020 № 285 «О введении чрезвычайного положения в Республике Казахстан»
Постановление Главного государственного санитарного врача Казахстана «О введении дополнительных мер по недопущению распространения коронавирусной инфекции в Республике Казахстан»
Постановление Главного государственного санитарного врача Республики Казахстан от 12 марта 2020 года № 19-ПГВр «Об усилении мер по недопущению распространения коронавирусной инфекции в Республике Казахстан»
Распоряжение Премьер-Министра Республики Казахстан от 27 января 2020 года № 10-р «О мерах по недопущению возникновения и распространения коронавирусной инфекции на территории Республики Казахстан» (с изменениями от 14.02.2020 г.)
Кыргызстан
Распоряжение Правительства Кыргызской Республики от 9 июня 2020 года № 210-р
Постановление Правительства Кыргызской Республики от 9 июня 2020 года № 315 «Об утверждении Программы «Финансирование субъектов предпринимательства»
Постановление Правительства Кыргызской Республики от 22 мая 2020 года № 271 "О внесении изменений в постановление Правительства Кыргызской Республики «О мерах по предотвращению угрозы возникновения и распространения коронавирусной инфекции (COVID-19) на территории Кыргызской Республики» от 17 марта 2020 года № 163"
Постановление Правительства Кыргызской Республики от 19 мая 2020 года № 256 "О вопросах обеспечения населения документами, удостоверяющими личность граждан Кыргызской Республики, иностранных граждан и лиц без гражданства"
Указ Президента Кыргызской Республики №71 от 14 апреля 2020 года «О внесении изменений в некоторые решения Президента Кыргызской Республики»
Указ Президента Кыргызской Республики №72 от 14 апреля 2020 года «О введении чрезвычайного положения на территории города Нарын и Ат-Башинского района Нарынской области Кыргызской Республики»
Приказ комендатуры города Бишкек от 30 марта 2020 года №15 «О дополнительных мерах по обеспечению режима чрезвычайного положения»
Приказ комендатуры города Бишкек от 26 марта 2020 года № 6пр
Указ Президента Кыргызской Республики от 24 марта 2020 года «О введении чрезвычайного положения на территории города Ош, Ноокатского и Кара-Суйского районов Ошской области Кыргызской Республики»
Указ Президента Кыргызской Республики от 24 марта 2020 года «О введении чрезвычайного положения на территории города Бишкек Кыргызской Республики»
Постановление Правительства Кыргызской Республики от 23 марта 2020 года № 178 «О мерах по обеспечению населения лекарственными средствами и медицинскими изделиями в связи с пандемией коронавирусной инфекции»
Указ Президента Кыргызской Республики от 23 марта 2020 года «О приостановлении мероприятий по реализации этапов избирательного процесса выборов депутатов местных кенешей Баткенской, Джалал-Абадской, Нарынской, Иссык-Кульской, Чуйской, Ошской областей и города Ош КР»
Постановление Правительства Кыргызской Республики от 22 марта 2020 года № 174 «О введении временного запрета на вывоз (экспорт) отдельных видов товаров из Кыргызской Республики»
Распоряжение Правительства Кыргызской Республики от 20 марта 2020 года № 92-р
Постановление от 19 марта 2020 года № 173 «О внесении изменений в постановление Правительства Кыргызской Республики «Об утверждении Положения о резервных фондах глав местных государственных администраций ‒ губернаторов областей и акимов районов Кыргызской Республики» от 11 апреля 2012 года № 238»
Распоряжение Правительства Кыргызской Республики от 19 марта 2020 года № 88-р
Распоряжение Правительства Кыргызской Республики от 17 марта 2020 года № 84-р
Постановление Правительства Кыргызской Республики от 12 марта 2020 года № 146 «О введении временного ограничения на проведение культурных, спортивных и других массовых мероприятий»
Молдова
В Молдове отменено чрезвычайное положение в области здравоохранения
НЧКОЗ Молдовы: о возвращении с 16 февраля к дифференцированным мерам защиты в зависимости от порога тревоги в каждом населенном пункте, установленного исходя из уровня заболеваемости
Постановление об объявлении в Молдове чрезвычайного положения опубликовано в "Monitorul Oficial"
С 27 декабря при въезде в Молдову из стран красной зоны обязательно представлять отрицательный ПЦР-тест
В Молдове продлили действие чрезвычайного положения в здравоохранении до 30 ноября
Постановление №57 от 17 июля 2021 г. Чрезвычайной национальной комиссии по общественному здоровью Молдовы
Постановление №35 от 27 ноября 2020 года Национальной комиссии общественного здоровья
Постановление №34 от 13 октября 2020 года Национальной комиссии общественного здоровья
Постановление №33 от 28 сентября 2020 г. Национальной чрезвычайной комиссии общественного здоровья
Постановление №32 от 24 сентября 2020 г. Национальной чрезвычайной комиссии общественного здоровья
Постановление №30 от 11 сентября 2020 г. Национальной чрезвычайной комиссии общественного здоровья
Постановление №29 от 7 сентября 2020 г. Национальной чрезвычайной комиссии общественного здоровья
Постановление №28 от 28 августа 2020 г. Национальной чрезвычайной комиссии общественного здоровья
Постановление №22 от 31 июля 2020 года Национальной чрезвычайной комиссии общественного здоровья
Постановление № 20 от 10.07.2020 года Национальной чрезвычайной комиссии общественного здоровья
Постановление Правительства Республики Молдова №494 от 08.07.2020 «Об утверждении Положения о государственных закупках, необходимых для профилактики и контроля инфекции COVID-19»
Постановление Правительства Республики Молдова № 466 от 03.07.2020 «О некоторых мерах по поощрению врачей и фармацевтов-резидентов, студентов высшего, послесреднего профессионально-технического и послесреднего нетретичного медицинского и фармацевтического образования, задействованных в контроле и борьбе с инфекцией COVID-19»
Постановление № 19 от 27.06.2020 года Национальной чрезвычайной комиссии общественного здоровья
Постановление № 18 от 24.06.2020 года Национальной чрезвычайной комиссии общественного здоровья
Постановление № 17 от 23.06.2020 года Национальной чрезвычайной комиссии общественного здоровья
Постановление № 16 от 18.06.2020 года Национальной чрезвычайной комиссии общественного здоровья
Постановление № 15 от 12.06.2020 года Национальной чрезвычайной комиссии общественного здоровья
Постановление № 14 от 03.06.2020 года Национальной чрезвычайной комиссии общественного здоровья
Постановление №13 от 29 мая 2020 года Национальной чрезвычайной комиссии общественного здоровья
Постановление Правительства Республики Молдова №315 от 20.05.2020 «О публичном медико-санитарном учреждении «Центр COVID-19 Кишинэу»
Распоряжение №17 от 13 апреля 2020 года Комиссии по чрезвычайным ситуациям Республики Молдова
Распоряжение №14 от 6 апреля 2020 года Комиссии по чрезвычайным ситуациям Республики Молдова
Распоряжение №6 от 27 марта 2020 года Комиссии по чрезвычайным ситуациям Республики Молдова
Распоряжение №1 от 18 марта 2020 года Комиссии по чрезвычайным ситуациям Республики Молдова
Постановление Правительства Республики Молдова от 16 марта 2020 года №171 «О внесении предложения об объявлении чрезвычайного положения»
Россия
Распоряжение Правительства Российской Федерации от 27 ноября 2020 года №3129-р о выделении более 1,4 млрд рублей на закупку медицинского транспорта для сельской местности
Распоряжение Правительства Российской Федерации от 23 ноября 2020 года №3073-р о включении вакцины от коронавируса в перечень жизненно важных препаратов
Распоряжение Правительства Российской Федерации от 18 ноября 2020 года №3013-р о снятии ограничений на въезд в Россию для членов семей иностранных спортсменов
Распоряжение Правительства Российской Федерации от 29 октября 2020 года №2805-р о выделении более 5 млрд рублей на бесплатные лекарства для больных с коронавирусом
Распоряжение Правительства Российской Федерации от 23 октября 2020 года № 2743-р о расширении перечня медицинских организаций, перепрофилированных для больных с коронавирусной инфекцией
https://стопкоронавирус.рф/ai/doc/575/attach/rasporyaxhenie_pravitelstva_rossijskoj_federacii_ot_03.10.2020_2557-r.pdf
Постановление Правительства Российской Федерации от 1 октября 2020 года №1580 о продлении действия ряда разрешительных документов
Постановление Правительства Российской Федерации от 1 октября 2020 года о продлении моратория на возбуждение дел о банкротстве №1587
Распоряжение Правительства Российской Федерации от 20 сентября 2020 года №2406-р о возобновлении авиасообщения с Белоруссией, Казахстаном, Киргизией и Кореей
Постановление Правительства Российской Федерации от 18 сентября 2020 г. № 1480 о расширении перечня медицинских товаров, не облагаемых НДС
Распоряжение Правительства Российской Федерации от 11 сентября 2020 года №2316-р
Постановление Правительства Российской Федерации от 9 сентября 2020 года №1381
Постановление Правительства Российской Федерации от 12 августа 2020 года №1211 "О внесении изменений в постановление Правительства Российской Федерации от 3 июня 2020 г. № 816"
Распоряжение Правительства Российской Федерации от 1 августа 2020 года №1996-р
Постановление от 20 июля 2020 года №1073 "Об утверждении Положения об особенностях на 2020 и 2021 годы исполнения и расторжения договора о реализации туристского продукта, заключенного по 31 марта 2020 года включительно, туроператором, осуществляющим деятельность в сфере внутреннего туризма, и (или) въездного туризма"
Постановление от 20 июля 2020 года №1078 "Об утверждении Положения об особенностях отмены либо переноса бронирования места в гостинице или ином средстве размещения в отношении оснований, порядка, сроков и условий такого переноса и (или) возврата заказчикам (потребителям) денежных сумм, уплаченных ими при бронировании, на 2020 и 2021 годы"
Постановление от 16 июля 2020 года №1066 "О внесении изменений в Правила предоставления субсидий из федерального бюджета российским кредитным организациям на возмещение недополученных ими доходов по кредитам, выданным в 2020 году системообразующим организациям и их дочерним обществам на пополнение оборотных средств"
Постановление от 16 июля 2020 года №1065 "Об особенностях применения в 2020 году Правил предоставления из федерального бюджета субсидий российским организациям на финансовое обеспечение части затрат на создание научнотехнического задела по разработке базовых технологий производства приоритетных электронных компонентов и радиоэлектронной аппаратуры"
Постановление от 15 июля 2020 года №1042 "Об утверждении Положения об особенностях на 2020 и 2021 годы исполнения и расторжения договора о реализации туристского продукта, заключенного по 31 марта 2020 года включительно, туроператором, осуществляющим деятельность в сфере внутреннего туризма, и (или) въездного туризма, и (или) выездного туризма"
Постановление от 4 июля 2020 года №988 "О внесении изменений в постановление Правительства Российской Федерации от 27 марта 2020 г. № 346"
Постановление от 2 июля 2020 года №976 "Об утверждении Правил предоставления в 2020 году из федерального бюджета субсидий субъектам малого и среднего предпринимательства и социально ориентированным некоммерческим организациям на проведение мероприятий по профилактике новой коронавирусной инфекции"
Распоряжение от 2 июля 2020 года №1724-р
Постановление от 27 июня 2020 года №941 "О внесении изменений в постановление Правительства Российской Федерации от 15 мая 2020 г. № 681"
Постановление от 26 июня 2020 года №926 "О внесении изменения в пункт 3 Правил предоставления в 2020 году иных межбюджетных трансфертов из федерального бюджета бюджетам субъектов Российской Федерации, источником финансового обеспечения которых являются бюджетные ассигнования резервного фонда Правительства Российской Федерации"
Распоряжение от 25 июня 2020 года №1671-р
Постановление от 24 июня 2020 года №915 "Об особенностях предоставления в 2020 году субсидий юридическим лицам (за исключением субсидий государственным (муниципальным) учреждениям) и индивидуальным предпринимателям, ведущим деятельность в отраслях российской экономики, в наибольшей степени пострадавших в условиях ухудшения ситуации в результате распространения новой коронавирусной инфекции"
Распоряжение от 23 июня 2020 года №1659-р
Постановление от 18 июня 2020 года №876 "О внесении изменений во Временные правила оформления листков нетрудоспособности, назначения и выплаты пособий по временной нетрудоспособности в случае карантина застрахованным лицам в возрасте 65 лет и старше"
Постановление от 11 июня 2020 года №849 "О внесении изменений в постановление Правительства Российской Федерации от 3 апреля 2020 г. № 440"
Постановление от 10 июня 2020 года №842 "Об особенностях проведения государственной итоговой аттестации по образовательным программам основного общего и среднего общего образования и вступительных испытаний при приеме на обучение по программам бакалавриата и программам специалитета в 2020 году"
Постановление от 10 июня 2020 года №844 "О внесении изменений в некоторые акты Правительства Российской Федерации"
Постановление от 3 июня 2020 года №816 "О временном порядке распределения в Российской Федерации некоторых лекарственных препаратов для медицинского применения, возможных к назначению и применению для лечения новой коронавирусной инфекции"
Постановление от 3 июня 2020 года №815 «Об утверждении Правил финансового обеспечения мероприятий по закупке, хранению и доставке средств индивидуальной защиты, медицинских изделий и средств дезинфекции с их последующей передачей на безвозмездной основе конечным получателям»
Постановление от 30 мая 2020 года №797 «Об утверждении Правил осуществления специальных выплат гражданам, принявшим на сопровождаемое или временное проживание (под временную опеку) инвалидов, престарелых граждан, детей-сирот и детей, оставшихся без попечения родителей»
Постановление от 29 мая 2020 года №784 «О внесении изменений в некоторые акты Правительства Российской Федерации»
Распоряжение от 22 мая 2020 года №1372-р
Распоряжение Правительства Российской Федерации от 12 апреля 2020 года №976-р
Постановление Правительства Российской Федерации от 12 апреля 2020 года №484
Распоряжение Правительства Российской Федерации от 10 апреля 2020 года №968-р «О внесении изменений в перечень отраслей российской экономики, в наибольшей степени пострадавших в условиях ухудшения ситуации в результате распространения новой коронавирусной инфекции»
Постановление Правительства Российской Федерации от 10 апреля 2020 года №478
Постановление Правительства Российской Федерации от 3 апреля 2020 года №430 «Об особенностях обращения медицинских изделий, в том числе государственной регистрации серии (партии) медицинского изделия»
Постановление Правительства Российской Федерации от 3 апреля 2020 года №431 «Об установлении особенностей обращения медицинских изделий и ограничений на осуществление оптовой и розничной торговли медицинскими изделиями и о перечне таких изделий»
Постановление Правительства Российской Федерации от 3 апреля 2020 года №432 «Об особенностях реализации базовой программы обязательного медицинского страхования в условиях возникновения угрозы распространения заболеваний, вызванных новой коронавирусной инфекцией»
Постановление Правительства Российской Федерации от 3 апреля 2020 года №433 «Об утверждении Положения об оказании социальной поддержки (помощи) российским гражданам, находящимся на территории иностранного государства и не имеющим возможности вернуться в Российскую Федерацию в связи с распространением новой коронавирусной инфекции»
Постановление Правительства Российской Федерации от 3 апреля 2020 года №443 «Об особенностях осуществления закупки в период принятия мер по обеспечению санитарно-эпидемиологического благополучия населения на территории Российской Федерации в связи с распространением новой коронавирусной инфекции»
Распоряжение Правительства Российской Федерации от 2 апреля 2020 года №846-р
Постановление от 2 апреля 2020 года №410 «Об утверждении Правил предоставления в 2020 году субсидий из федерального бюджета российским кредитным организациям на обеспечение отсрочки платежа по кредитам, выданным субъектам малого и среднего предпринимательства»
Постановление Правительства Российской Федерации от 2 апреля 2020 года №415
Постановление Правительства Российской Федерации от 2 апреля 2020 года №409 «Определены меры по обеспечению устойчивого развития экономики в связи с распространением новой коронавирусной инфекции»
Федеральный закон от 01.04.2020 № 100-ФЗ «О внесении изменений в Уголовный кодекс Российской Федерации и статьи 31 и 151 Уголовно-процессуального кодекса Российской Федерации»
Постановление от 31 марта 2020 года №385 «О введении временного количественного ограничения на вывоз зерновых культур за пределы территории Российской Федерации в государства, не являющиеся членами Евразийского экономического союза, и установлении случая, при котором временное периодическое таможенное декларирование товаров не применяется»
Распоряжение Правительства Российской Федерации от 28 марта 2020 года №767-р
Распоряжение Правительства Российской Федерации от 27 марта 2020 года №763-р
Распоряжение Правительства Российской Федерации от 27 марта 2020 года №762-р
Распоряжение Правительства Российской Федерации от 25 марта 2020 года №723-р
Указ Мэра Москвы от 26 марта 2020 года № 31-УМ «О внесении изменений в указ Мэра Москвы от 5 марта 2020 г. № 12-УМ»
Указ Президента Российской Федерации от 25.03.2020 № 206 «Об объявлении в Российской Федерации нерабочих дней»
Указ Президента Российской Федерации от 25.03.2020 № 205 «О переносе даты общероссийского голосования по вопросу одобрения изменений в Конституцию Российской Федерации»
Постановление Правительства Российской Федерации от 21 марта 2020 года №323 «Об авансировании государственных контрактов на осуществление Министерством промышленности и торговли Российской Федерации закупок аппаратов искусственной вентиляции легких и экстракорпоральной мембранной оксигенации, включающих работы и услуги по их доставке в медицинские организации в субъектах Российской Федерации»
Постановление Правительства Российской Федерации от 21 марта 2020 года №324
Распоряжение Правительства Российской Федерации от 20 марта 2020 года №685-р
Распоряжение Правительства Российской Федерации от 19 марта 2020 года №672-р
Распоряжение Правительства Российской Федерации от 19 марта 2020 года №670-р
Постановление Правительства Российской Федерации от 18 марта 2020 года №294 «Об утверждении Временных правил оформления листков нетрудоспособности, назначения и выплаты пособий по временной нетрудоспособности в случае карантина»
Распоряжение Правительства Российской Федерации от 16 марта 2020 года №635-р
Постановление Правительства РФ от 14 марта 2020 г. N 285 «О Координационном совете при Правительстве Российской Федерации по борьбе с распространением новой коронавирусной инфекции на территории Российской Федерации»
Таджикистан
Узбекистан
Информация о вводимых дополнительных карантинных мерах в целях недопущения распространения в Узбекистане нового штамма коронавирусной инфекции «омикрон»
Указ Президента Республики Узбекистан от 12 ноября 2020 года № УП-6110 «О мерах по внедрению принципиально новых механизмов в деятельность учреждений первичной медико-санитарной помощи и дальнейшему повышению эффективности проводимых в системе здравоохранения реформ»
Постановление Президента Республики Узбекистан от 12 ноября № ПП-4891 «о дополнительных мерах по обеспечению общественного здоровья путем дальнейшего повышения эффективности работ по медицинской профилактике»
Указ Президента Республики Узбекистан от 30 октября 2020 года № УП-6099 «О мерах по широкому внедрению здорового образа жизни и дальнейшему развитию массового спорта»
Указ Президента Республики Узбекистан от 21 октября № УП-6091 «о мерах по дальнейшему расширению финансовой поддержки экспортной деятельности»
Постановление Кабинета Министров Республики Узбекистан от 24 сентября 2020 года №582 "О внесении изменений и дополнений в постановление Кабинета Министров Республики Узбекистан от 22 июля 2020 г. № 449 «О мерах по упорядочению оборота лекарственных средств, медицинских изделий и медицинской техники в период пандемии по коронавирусу"
Постановление Президента Республики Узбекистан 21 августа 2020 года № ПП-4812 «О дополнительных мерах по поддержке отечественных производителей»
Указ Президента Республики Узбекистан 18 августа 2020 года № УП-6042 «О дополнительных мерах по дальнейшему развитию экспортного и инвестиционного потенциала республики»
Указ Президента Республики Узбекистан № УП-6029 от 20 июля "О дополнительных мерах поддержки населения, субъектов предпринимательства, сферы общественного питания, торговли и услуг для снижения негативного воздействия коронавирусной пандемии"
Постановление Президента Республики Узбекистан №ПП-4772 от 2 июля 2020 года "О мерах по реализации проекта «Принятие неотложных мер по противодействию коронавирусной инфекции COVID-19 в Узбекистане» при участии Всемирного банка"
Постановление Президента Республики Узбекистан №ПП-4755 от 19 июня 2020 года "О дополнительных мерах по развитию сферы туризма при строгом соблюдении требований усиленного режима санитарно-эпидемиологической безопасности"
Указ Президента Республики Узбекистан «О неотложных мерах поддержки сферы туризма для снижения негативного воздействия коронавирусной пандемии» от 28 мая 2020 г., № УП-6002
Постановление Кабинета Министров Республики Узбекистан «О внесении изменений в Постановление Кабинета Министров от 23 апреля 2020 г. № 247 «О временном ограничении экспорта сырья для производства медицинских изделий и импорта цементной продукции в период пандемии коронавируса» от 22 мая 2020 г., № 309
Постановление Кабинета Министров Республики Узбекистан «О внесении изменений и дополнения в некоторые решения Правительства Республики Узбекистан (Указ Президента Республики Узбекистан от 3 апреля 2020 года № уп-5978 «О дополнительных мерах поддержки населения, отраслей экономики и субъектов предпринимательства в период коронавирусной пандемии») от 20 мая 2020 г., № 307
Указ Президента Республики Узбекистан «Об очередных мерах по поддержке населения и субъектов предпринимательства в период коронавирусной пандемии» от 18 мая 2020 г., № УП-5996
Указ Президента Республики Узбекистан №УП-5978 от 3 апреля 2020 «О дополнительных мерах поддержки населения, отраслей экономики и субъектов предпринимательства в период коронавирусной пандемии»
Постановление Президента Республики Узбекистан от 26 марта 2020 года «О дополнительных мерах по предупреждению широкого распространения коронавирусной инфекции в Республике Узбекистан»
Постановление Президента Республики Узбекистан от 27 марта 2020 года «О дополнительных мерах по обеспечению потребности населения в лекарственных средствах, изделиях медицинского назначения, медицинской технике и товарах первой необходимости»
Постановление Президента Республики Узбекистан от 26 марта 2020 года №ПП–4652 «О дополнительных мерах по поддержке медицинских работников и работников санитарно-эпидемиологической службы, привлеченных к противодействию распространению коронавирусной инфекции»
Постановление Кабинета Министров Республики Узбекистан № 176 «О дополнительных мерах против распространения коронавирусной инфекции»
Указ Президента Республики Узбекистан «О первоочередных мерах по смягчению негативного воздействия на отрасли экономики коронавирусной пандемии и глобальных кризисных явлений»
Распоряжение Президента Республики Узбекистан от 29.01.2020 г. N Р-5537 «Об образовании Специальной республиканской комиссии по подготовке Программы мер по предупреждению завоза и распространения нового типа коронавируса в Республике Узбекистан»
Украина
Закон № 530-IX относительно предупреждения возникновения и распространения коронавирусной болезни (COVID-19)
Закон №531-IX «О внесении изменений в некоторые законы Украины, направленные на повышение доступности лекарств, медицинских изделий и вспомогательных средств к ним, которые закупаются лицом, уполномоченным на осуществление закупок в сфере здравоохранения»
Информационный бюллетень № 113 (27 мая – 2 июня 2022 года)
Информационный бюллетень № 112 (20–26 мая 2022 года)
Информационный бюллетень № 111 (13–19 мая 2022 года)
Информационный бюллетень № 110 (6–12 мая 2022 года)
Информационный бюллетень № 109 (29 апреля – 5 мая 2022 года)
Информационный бюллетень № 108 (22–28 апреля 2022 года)
Информационный бюллетень № 107 (15–21 апреля 2022 года)
Информационный бюллетень № 106 (8–14 апреля 2022 года)
Информационный бюллетень № 105 (1–7 апреля 2022 года)
Информационный бюллетень № 104 (25–31 марта 2022 года)
Информационный бюллетень № 103 (18–24 марта 2022 года)
Информационный бюллетень № 102 (11–17 марта 2022 года)
Информационный бюллетень № 101 (4–10 марта 2022 года)
Информационный бюллетень № 100 (25 февраля - 3 марта 2022 года)
Информационный бюллетень № 99 (18–24 февраля 2022 года)
Информационный бюллетень № 98 (11–17 февраля 2022 года)
Информационный бюллетень № 97 (4–10 февраля 2022 года)
Информационный бюллетень № 96 (28 января – 3 февраля 2022 года)
Информационный бюллетень № 95 (21–27 января 2022 года)
Информационный бюллетень № 94 (14–20 января 2022 года)
Информационный бюллетень № 93 (3–13 января 2022 года)
Информационный бюллетень № 92 (24–30 декабря 2021 года)
Информационный бюллетень № 91 (17–23 декабря 2021 года)
Информационный бюллетень № 90 (10–16 декабря 2021 года)
Информационный бюллетень № 89 (3–9 декабря 2021 года)
Информационный бюллетень № 88 (26 ноября – 2 декабря 2021 года)
Информационный бюллетень № 87 (19 – 25 ноября 2021 года)
Информационный бюллетень № 86 (12 – 18 ноября 2021 года)
Информационный бюллетень № 85 (5 – 11 ноября 2021 года)
Информационный бюллетень № 84 (29 октября – 4 ноября 2021 года)
Информационный бюллетень № 83 (22 – 28 октября 2021 года)
Информационный бюллетень № 82 (15 – 21 октября 2021 года)
Информационный бюллетень № 81 (8 – 14 октября 2021 года)
Информационный бюллетень № 80 (1 – 7 октября 2021 года)
Информационный бюллетень № 79 (23 – 30 сентября 2021 года)
Информационный бюллетень № 78 (17 – 23 сентября 2021 года)
Информационный бюллетень № 77 (10 – 16 сентября 2021 года)
Информационный бюллетень № 76 (3 – 9 сентября 2021 года)
Информационный бюллетень № 75 (27 августа – 2 сентября 2021 года)
Информационный бюллетень № 74 (20 – 26 августа 2021 года)
Информационный бюллетень № 73 (13 – 19 августа 2021 года)
Информационный бюллетень № 72 (6 – 12 августа 2021 года)
Информационный бюллетень № 71 (30 июля – 5 августа 2021 года)
Информационный бюллетень № 70 (23 – 29 июля 2021 года)
Информационный бюллетень № 69 (16 – 22 июля 2021 года)
Информационный бюллетень № 68 (9 – 15 июля 2021 года)
Информационный бюллетень № 67 (2 – 8 июля 2021 года)
Информационный бюллетень № 66 (25 июня – 1 июля 2021 года)
Информационный бюллетень № 65 (18 – 24 июня 2021 года)
Информационный бюллетень № 64 (11 – 17 июня 2021 года)
Информационный бюллетень № 63 (4 – 10 июня 2021 года)
Информационный бюллетень № 62 (28 мая – 3 июня 2021 года)
Информационный бюллетень № 61 (21 – 27 мая 2021 года)
Информационный бюллетень № 60 (14 – 20 мая 2021 года)
Информационный бюллетень № 59 (7 – 13 мая 2021 года)
Информационный бюллетень № 58 (30 апреля – 6 мая 2021 года)
Информационный бюллетень № 57 (23 – 29 апреля 2021 года)
Информационный бюллетень № 56 (16 – 22 апреля 2021 года)
Информационный бюллетень № 55 (9 – 15 апреля 2021 года)
Информационный бюллетень № 54 (2 – 8 апреля 2021 года)
Информационный бюллетень № 53 (26 марта - 1 апреля 2021 года)
Информационный бюллетень № 52 (19 – 25 марта 2021 года)
Информационный бюллетень № 51 (12 – 18 марта 2021 года)
Информационный бюллетень № 50 (5 – 11 марта 2021 года)
Информационный бюллетень № 49 (26 февраля – 4 марта 2021 года)
Информационный бюллетень № 48 (19 – 25 февраля 2021 года)
Информационный бюллетень № 47 (12 – 18 февраля 2021 года)
Информационный бюллетень № 46 (5 – 11 февраля 2021 года)
Информационный бюллетень № 45 (29 января – 4 февраля 2021 года)
Информационный бюллетень № 44 (22 – 28 января 2021 года)
Информационный бюллетень № 43 (15 – 21 января 2021 года)
Информационный бюллетень № 42 (7 – 14 января 2021 года)
Информационный бюллетень № 41 (31 декабря 2020 – 6 января 2021 года)
Информационный бюллетень № 40 (25 – 30 декабря 2020 года)
Информационный бюллетень №39 (18-24 декабря 2020 года)
Информационный бюллетень №38 (11-17 декабря 2020 года)
Информационный бюллетень №37 (4-10 декабря 2020 года)
Информационный бюллетень №36 (27 ноября - 3 декабря 2020 года)
Информационный бюллетень №35 (20-26 ноября 2020 года)
Информационный бюллетень №34 (13-19 ноября 2020 года)
Информационный бюллетень №33 (6-12 ноября 2020 года)
Информационный бюллетень №32 (30 октября - 5 ноября 2020 года)
Информационный бюллетень №31 (23-29 октября 2020 года)
Информационный бюллетень №30 (16-22 октября 2020 года)
Информационный бюллетень №29 (9-15 октября 2020 года)
Информационный бюллетень №28 (2-8 октября 2020 года)
Информационный бюллетень №27 (25 сентября - 1 октября 2020 года)
Информационный бюллетень №26 (18-24 сентября 2020 года)
Информационный бюллетень №25 (11-17 сентября 2020 года)
Информационный бюллетень №24 (4-10 сентября 2020 года)
Информационный бюллетень №23 (28 августа - 3 сентября 2020 года)
Информационный бюллетень №22 (21-27 августа 2020 года)
Информационный бюллетень №21 (14-20 августа 2020 года)
Информационный бюллетень №20 (7-13 августа 2020 года)
Информационный бюллетень №19 (31 июля - 6 августа 2020 года)
Информационный бюллетень №18 (24-30 июля 2020 года)
Информационный бюллетень №17 (17-23 июля 2020 года)
Информационный бюллетень №16 (10-16 июля 2020 года)
Информационный бюллетень №15 (3-9 июля 2020 года)
Информационный бюллетень №14 (26 июня - 2 июля 2020 года)
Информационный бюллетень №13 (19-25 июня 2020 года)
Информационный бюллетень №12 (12-18 июня 2020 года)
Информационный бюллетень №11 (5-11 июня 2020 года)
Информационный бюллетень №10 (29 мая - 4 июня 2020 года)
Информационный бюллетень №9 (22-28 мая 2020 года)
Информационный бюллетень №8 (15-21 мая 2020 года)
Информационный бюллетень №7 (8-14 мая 2020 года)
Информационный бюллетень №6 (1-7 мая 2020 года)
Информационный бюллетень №5 (24-30 апреля 2020 года)
Information Bulletin No. 4 (17–23 April 2020), перевод Европейского регионального бюро ВОЗ
Информационный бюллетень №4 (17-23 апреля 2020 года)
Информационный бюллетень №3 (10-16 апреля 2020 года)
Информационный бюллетень №2 (3-9 апреля 2020 года)
Информационный бюллетень №1 (26 марта - 2 апреля 2020 года)